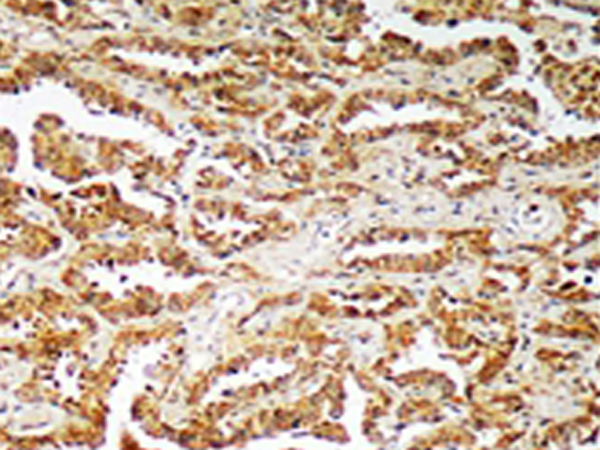

中文名稱:兔抗GIT1多克隆抗體
儲(chǔ) 存: 冷凍(-20℃) 避光
相關(guān)類別: 一抗
|
Background: |
GTPase-activating protein for the ADP ribosylation factor family. May serve as a scaffold to bring together molecules to form signaling modules controlling vesicle trafficking, adhesion and cytoskeletal organization. Increases the speed of cell migration, as well as the size and rate of formation of protrusions, possibly by targeting PAK1 to adhesions and the leading edge of lamellipodia. Sequesters inactive non-tyrosine-phosphorylated paxillin in cytoplasmic complexes. |
|
Applications: |
WB, IHC |
|
Name of antibody: |
GIT1 |
|
Immunogen: |
Synthesized peptide derived from C-terminal of human GIT1. |
|
Full name: |
G protein-coupled receptor kinase interacting ArfGAP 1 |
|
Synonyms: |
0 |
|
SwissProt: |
Q9Y2X7 |
|
IHC positive control: |
Human lung carcinoma tissue |
|
IHC Recommend dilution: |
50-100 |
|
WB Predicted band size: |
84 kDa |
|
WB Positive control: |
Hela cells, Jurkat cells and HepG2 cells lysates |
|
WB Recommended dilution: |
500-3000 |

購(gòu)物車
幫助
021-54845833/15800441009
